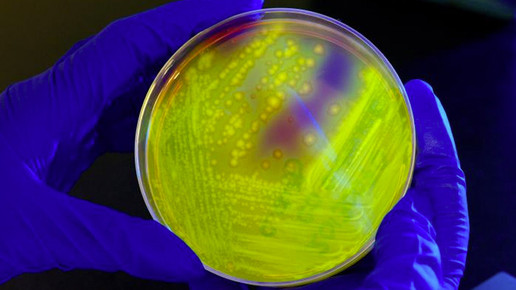
700.000 Tote jährlich durch Antibiotika-Resistenz

700.000 Tote jährlich durch Antibiotika-Resistenz
Rund 700.000 Menschen sterben nach Schätzungen jedes Jahr weltweit an Infektionen, gegen die keine Antibiotika mehr helfen. Die Zahl können auf zehn Millionen Menschen im Jahr steigen, wenn Forscher das wachsende Problem der Resistenzen von Bakterien gegen Antibiotika nicht in den Griff bekämen, heißt es in einer Studie des Mahidol Oxford Research Centre (MORU) in Bangkok und des Infectious Diseases Data Observatory (IDDO) in Oxford.
In vielen Ländern breiten sich Bakterien aus, die gegen Antibiotika immun sind. In den schlimmsten Fällen haben Ärzte dann keine Mittel mehr, um lebensgefährliche Infektionen zu stoppen.
Die Wissenschaftler errechneten, dass die zunehmenden Resistenzen für die Gesellschaft schon jetzt auch eine immense finanzielle Bürde sind. Sie haben die Kosten von Antibiotikaresistenzen – etwa höhere Todesraten, Einkommensausfälle und Mehraufwand für Diagnosen – zum Vergleich auf jeweils eine einzelne Behandlung mit Antibiotika heruntergerechnet.
In Thailand kostet demnach eine mehrtägige Behandlung mit dem Breitband-Antibiotikum Amoxicillin weniger als zwei Dollar, die Kosten durch Resistenzen beliefen sich aber auf mehr als das Fünffache. In den USA koste eine Behandlung mit demselben Mittel weniger als zehn Dollar, die Resistenzkosten lägen bei 18,60 Dollar. Hochgerechnet auf ein ganzes Land kommen so Millionenbeträge zusammen.

APOTHEKE ADHOC Debatte